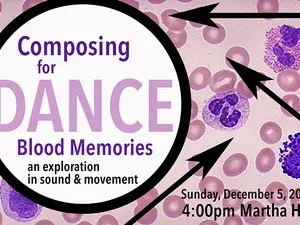
Composing for Dance

Event Calendar
Pick a DateProposed Staff Council Feedback Forum
We invite staff to provide feedback on the mission, goals, and structure of the proposed staff council. This will be an opportunity to ask questions and get updates on the work of Shared Governance. This is one of three sessions this week.
Reading: Muriel Leung
 Literature Evenings—Fall 2021
Literature Evenings—Fall 2021
Muriel Leung is the author of Imagine Us, The Swarm (Nightboat Books), Bone Confetti (Noemi Press), and Images Seen to Images Felt (Antenna) in collaboration with artist Kristine Thompson.
Webinar: Sexual Misconduct and the Title IX Process
Webinar on Sexual Misconduct and the Title IX Process
Student Office Hours with Dr. Alfredo Medina
Cabinet Office Hours—Fall 2021-Spring 2022Walk-ins are welcome, or to schedule an appointment with Dr. Medina, please email melissasmith@bennington.edu. Dr. Medina is available to meet outside of Student Office Hours by appointment as well.
Dr. Deborah Willis
 Visual Arts Lecture Series (VALS)—Fall 2021
Visual Arts Lecture Series (VALS)—Fall 2021
OPEN TO THE PUBLIC | A Visual Arts Lecture Series presentation by Dr. Deborah Willis.
Middlebury Language Schools Information Session
Learn more about the Middlebury Language Schools and the application process for Bennington students. A brief overview of Middlebury's 12 language programs along with the Bennington fellowship opportunity will be provided followed by a Q&A session.
Those Behind the Scenes Exhibition
A series of photographs of Bennington staff members aimed to introduce students to staff in a safe way and to acknowledge work that goes behind the scenes when running a college.
Staff Feedback Forum for Proposed Staff Council
We invite staff to provide feedback on the mission, goals, and structure of the proposed staff council. This will be an opportunity to ask questions and get updates on the work of Shared Governance. This is one of three sessions this week.
Open Office Hours with Dr. Li-Chen Chin, Dean of Student Life
Cabinet Office Hours—Fall 2021-Spring 2022Li-Chen Chin, Dean of Student Life, will hold open office hours for students every Wednesday. Please feel free to drop in, no appointment needed.
A Field Study
OPEN TO THE PUBLIC | An invitation to Xiao Ma's solo show at W.Collective in Downtown Bennington, which includes a set of photos they have collected throughout their time in Bennington called, "A Field Study".
Reading: Anaïs Duplan
 Literature Evenings—Fall 2021
Literature Evenings—Fall 2021
Anaïs Duplan is a trans* poet, curator, and artist. He is the author of forthcoming book I NEED MUSIC (Action Books, 2021), a book of essays, Blackspace: On the Poetics of an Afrofuture (Black Ocean, 2020), a full-length poetry collection, Take This Stallion (Brooklyn Arts Press, 2016), and a chapbook, Mount Carmel and the Blood of Parnassus (Monster House Press, 2017).
Music Festival
 Carriage Barn Music Series | Fall 2021
Carriage Barn Music Series | Fall 2021
The Bennington College annual Music Festival is an eclectic program of student compositions and performances across the spectrum.
Staff Feedback Forum for Proposed Staff Council
We invite staff to provide feedback on the mission, goals, and structure of the proposed staff council. This will be an opportunity to ask questions and get updates on the work of Shared Governance. This is one of three sessions this week.
Open Office Hours with Maurice Hall, Provost
Cabinet Office Hours—Fall 2021-Spring 2022Students are invited to walk-in open office hours with Maurice Hall, Provost.
Sound Binge

Sound Binge features student work from: Experimental Sound Practices, Composing for Instruments, and Remote but Intensely Collaborative Composition.
Future Mental Health and Wellness and Self-Governance at Bennington
A conversation on the Future Mental Health and Wellness and Self-Governance at Bennington. This hybrid event will take place in Tishman Lecture Hall with a virtual viewing option.
Jazz Ensemble

Class concert by Bennington's Jazz Ensemble, led by visiting faculty Jen Allen.
Too Much Light Makes the Baby Go Blind: 30 Neo-Futurist Plays in 60 Minutes by Greg Allen

An exciting ensemble experiment, presenting 30 short plays in just 60 minutes. The audience is given a "menu" of numbered play titles so that they may choose the performance order by calling out their number.
Works in Progress (WIP) Dance Concert
Performance of student dance works in progress.
Composing for the Choir

Performance by students of Kitty Brazelton's Composing for the Choir.
Key to Songs Cabaret

End-of-term Cabaret performance by students in Nick Brooke's Key to Songs course.
"Hermit Songs" Song Cycle Performance

Vera Much performs "Hermit Songs" accompanied by Yoshiko Sato on piano.
Winter Wreath Making Workshop with Colie Collen of Flower Scout

OPEN TO THE PUBLIC | Join us for a winter wreath making workshop with Colie Collen of Flower Scout Floral & Garden Design.
Composing for Dance
End-of-term performance by students in Michael Wimberly's Composing for Dance course.